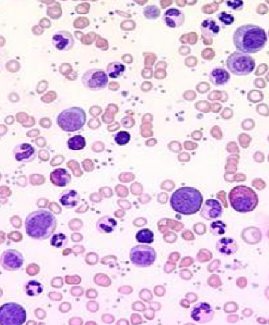

A hemophilic patient presented with an abdominal mass, fever and cough
DOI:
https://doi.org/10.3329/bsmmuj.v11i1.35585Keywords:
Abdominal mass, Case Presentation, Cough, Fever, HemophiliaAbstract
This article has no abstract. The first 100 words appear below:
A 30 year old male patient hailing from Jatrabari, Dhaka, the capital city of Bangladesh reported to the Department of Hematology, Armed forces Institute of Pathology, Dhaka Cantonment for the follow-up checkup of hemophilia A by assessing the factor VIII level. The patient had been suffering from mild rise of temperature, cough and weight loss for the last three months. So, he wanted to consult with a hematologist of the department. The concerned hematologist took detailed history of the patient and performed physical examination. History of the patient revealed cough, fever and mild weight loss for the last three months.
Downloads
703
139
Downloads
Published
How to Cite
Issue
Section
License
Copyright (c) 2018 Mohammad Mizanur Rahman, Lutfunnahar Khan, Mohammad Shahidul Islam, Md. Monirul Islam, Debashish Saha

This work is licensed under a Creative Commons Attribution-NonCommercial 4.0 International License.